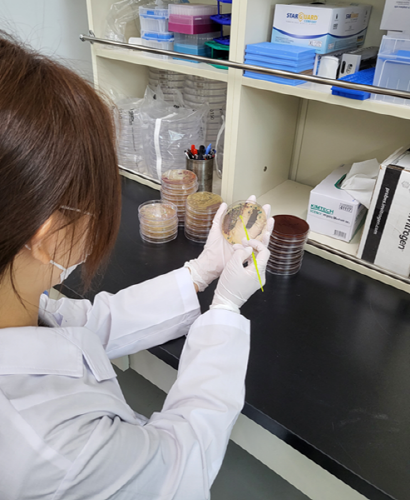

군산 내‧외항 등 6개 지점에서 해수·갯벌·어패류를 대상으로 오는 10월까지 매주 병원성 비브리오균 모니터링이 실시된다.
전북특별자치도 보건환경연구원은 2일 여름철 기온 상승으로 비브리오균 증식이 우려됨에 따라 군산·고창·부안 등 서해안 3개 시군 16개 지점에서 해수·갯벌·어패류를 대상으로 10월까지 매주 병원성 비브리오균 모니터링을 실시한다고 밝혔다.
군산의 경우 서수어판장, 구암하구, 내‧외항, 비응항, 도선장 6개 지점에서 진행된다.
비브리오 패혈증은 해수 온도가 상승하는 여름철에 집중적으로 발생하는 감염병으로 서해안 지역 해수와 갯벌, 어패류에서 주로 검출된다.
특히 간 질환자, 면역저하자 등 고위험군이 감염될 경우 패혈증으로 진행돼 치사율이 50%에 달하는 위험한 질병이다.
지난해 전북보건환경연구원이 수행한 897건의 조사에서 비브리오 패혈증균이 3.12% 검출됐으며 특히 지난해 4월 첫 검출사례가 확인돼 지난 2023년보다 2주가량 빠르게 나타났다.
전북보건환경연구원에 따르면 지난해 군산에선 총 335건의 조사가 진행됐으며 그중 16건에서 비브리오 패혈증균이 검출됐다.
이에 따라 도는 올해 4월부터 해양 감염병 확산을 방지하기 위한 선제적 대응에 나선다.
비브리오 패혈증을 예방하려면 ▲어패류는 반드시 85℃ 이상에서 충분히 가열 후 섭취하고 ▲5℃ 이하에서 저온 보관해야 하며 ▲해수에 손이나 피부 상처가 닿지 않도록 주의해야 한다.
전북보건환경연구원 관계자는 “기후 온난화로 해양환경이 변화하면서 비브리오균 증식 가능성이 더욱 커지고 있다”며 “지속적 감시와 유행 분석을 통해 감염병 발생을 조기에 인식하고 신속한 대응으로 확산을 막을 수 있도록 최선을 다하겠다”고 강조했다.
















